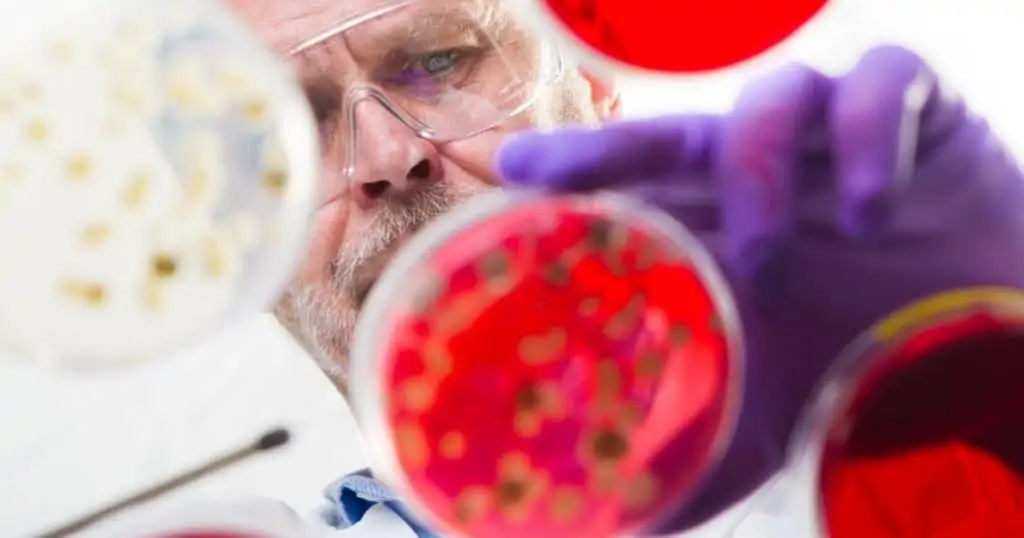

We’d like to welcome QA Consulting’s new Senior Quality and Microbiology Consultant, Adrienne Schroll! We’re thrilled to introduce Adrienne Schroll,…
We’d like to welcome QA Consulting’s new Senior Quality and Microbiology Consultant, Adrienne Schroll! We’re thrilled to introduce Adrienne Schroll,…
Author: Sallie McLaughlin, Senior Microbiology Consultant EN 17141:2020 Cleanrooms and associated controlled environments – Biocontamination control, introduced in August of…
Author: Amber Hilfiger, Director of Operations and Senior Engineering Consultant A biological evaluation report (BER) is a collective summary of…
Assessing bioburden is a critical process monitoring step in the manufacturing of sterile medical devices. A product’s natural bioburden is…
Important ST72:2019 updates can help ensure successful 510(k) submissions or avoid non-conformances The American National Standards Institute (ANSI) and the…
The FDA issued a long-awaited final guidance Use of International Standard ISO 10993-1, Biological evaluation of medical devices – Part…